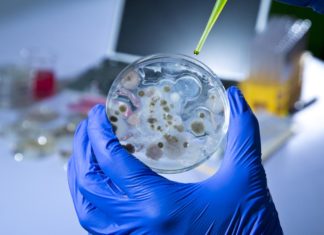
Rapid Legionella Detecting Microchip Developed Research Associate (Trainee) Position Vacant @ TERI

Biotecnika Times – Newsletter 27.03.2018 – UPSC Drug Controller Job, Rs....
Biotecnika Times - UPSC Drug Controller Job, Rs. 1.77 Lakh p.m.
UPSC Govt Job Recruitment - Drugs Controller Posts Vacant
Govt job for msc and bsc...
Bait, Hook, Destroy: Titanium Nanoparticles Embedded Mat Absorbs Pollutants from Water
Bait, Hook, Destroy: Titanium Nanoparticles Embedded Mat Absorbs Pollutants from Water
While many parts of the world face major challenges due to limited freshwater availability,...
Scientists Turn Cow & Elephant Poop to Paper
Scientists Turn Cow & Elephant Poop to Paper
We've all received statements from our banks, telecommunication and utilities companies with a simple message at the...
Rapid Legionella Detecting Microchip Developed
Rapid Legionella Detecting Microchip Developed
Increasing numbers of legionellosis outbreaks within the last years have shown that Legionella are a growing challenge for public health. After Legionella grows and multiplies...
Three-in-One Aptamer-siRNA Chimera Used to Target Breast Cancer in Mice
Three-in-One Aptamer-siRNA Chimera Used to Target Breast Cancer in Mice
20%–30% of breast cancer is characterized by HER2 overexpression that correlates with poor prognosis, high...
Personalized Diagnostic Kit for Breast Cancer Patients Receives CE Mark
Personalized Diagnostic Kit for Breast Cancer Patients Receives CE Mark
US-Dutch biotech Agendia has now received a CE Mark for its next-generation sequencing-based MammaPrint BluePrint...
Mutations in Regulatory Elements Linked to Neurodevelopmental Disorder
Mutations in Regulatory Elements Linked to Neurodevelopmental Disorder
42% of patients with severe developmental disorders carry pathogenic de novo mutations in coding sequences. But this role of de...
Check your Mastery Over CRISPR Tech with this Free Test
CRISPR Technology is an upcoming field and has vast potential. Young Scientists if putting their minds in this tech can own various Patents easily....
R&D Research Scientist Post for PhD Candidates @ Reliance
R&D Research Scientist Post for PhD Candidates @ Reliance
PhD Biology job vacancy at Reliance Industries. Reliance 2018 March research jobs for PhD biology candidates....
Internship Program For Life Science Candidates @ WWF, India
Internship Program For Life Science Candidates @ WWF, India
WWF, India Internship Program 2018 Official Notification. World Wildlife Fund Internship Program 2018 Official Notification. Red Panda Conservation Internship Program 2018...
PhD Program Admissions 2018 @ INST, Mohali
PhD Program Admissions 2018 @ INST, Mohali
Official notification for PhD Program Admissions 2018 at INST, Mohali. Institute of Nano Science and Technology (INST) PhD Program Admissions 2018. Institute of...
Biotecnika Times – Newsletter 26.03.2018 – FDA & United Nations Hiring
Biotecnika Times - FDA & United Nations Hiring. Govt Job @ DRDO
United Nations Volunteers Project Associate - Conservation Position Vacant
United Nations India Careers 2018...
Go Bananas with Ice Cream- Scientists Produce No-Melt Ice Creams Using...
Go Bananas with Ice Cream- Scientists Produce No-Melt Ice Creams Using Banana Extract
You’ve clearly been living under a rock if you haven’t heard of...
An Engineered Mix of Bacteria/Archaea to Shed Light on Evolution
An Engineered Mix of Bacteria/Archaea to Shed Light on Evolution
A frequently quoted hypothesis on the origin of the three domains of life (Archaea, Bacteria,...
Novartis, Harvard, Dana-Farber Join Hands for Cancer Immunotherapy Development
Novartis, Harvard, Dana-Farber Join Hands for Cancer Immunotherapy Development
Novartis is now teaming up with scientists at the Wyss Institute for Biologically Inspired Engineering at...
Parkinson’s Gene Mutation Found to Initiate the Disease Outside the Brain
Parkinson's Gene Mutation Found to Initiate the Disease Outside the Brain
Missense mutations in the leucine rich repeat kinase 2 (LRRK2) gene result in late-onset...
Scientists Discover Switch that Initiates Conversion of Blood Cells to Stem...
Scientists Discover Switch that Initiates Conversion of Blood Cells to Stem Cells
Over the past decade, advances in high-throughput transcriptomics and DNA occupancy analyses have...
Look! Something’s Fishy: SoFi the Robot Fish to Help Us Better...
Look! Something’s Fishy: SoFi the Robot Fish Helps Us Understand Sea
Closeup exploration of underwater life requires new forms of interaction, using biomimetic creatures that...
Central University of Tamil Nadu MSc/MPhil/PhD/Integrated M.Sc Admissions 2018-2019
Central University of Tamil Nadu - Admissions 2018-2019
Central University of Tamil Nadu - Admissions 2018-2019 Official Notification. MSc/BSc/M.Phil and PhD Admissions 2018-2019. Admissions 2018-2019 at...
Biotecnika Times – 100 Govt of Sri Lanka Presidential Scholarships
Biotecnika Times - 100 Govt of Sri Lanka Presidential Scholarships
100 Govt of Sri Lanka Presidential Scholarships 2018 - Application Open
Indian nationals are eligible to...